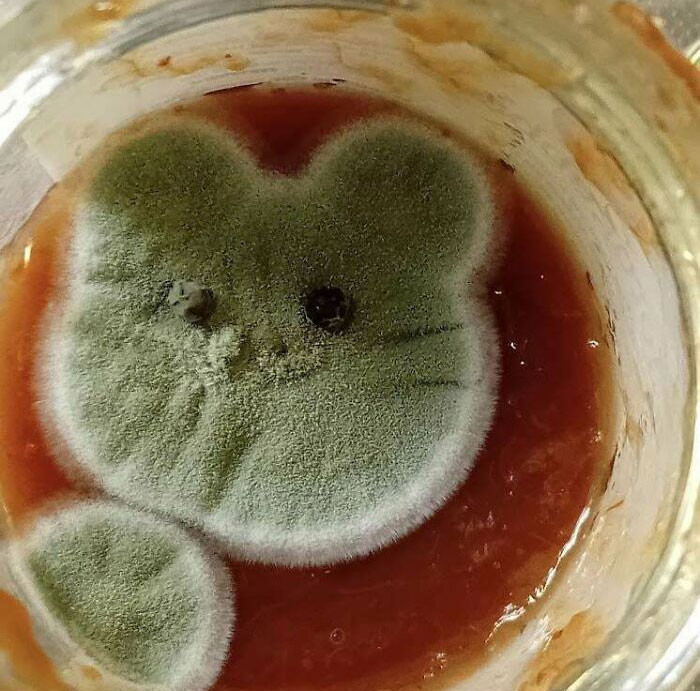

И так сойдет. На фото показали плесень, которой зачем-то дали разрастись
06 октября 2023 в 10:19
С плесенью можно бороться, а можно холить и лелеять. Хотя ничего полезного обычно в ней нет, более того, для здоровья она часто опасна или как минимум вызывает аллергию. Тем не менее встречаются люди, которые не стремятся бороться с плесенью, а иногда даже потворствуют ее развитию. В фотоподборке Boredpanda — такие примеры.
Произведение искусства? Нет. Был взят образец с подошвы обуви, а потом в лабораторных условиях вырастили все, что там было. К вопросу о том, стоит ли ходить дома в уличной обуви
Немного кошачьей еды. Которая сама может съесть кошку
Это фото от специалиста, который занимается уничтожением плесени в домах. Говорит, один из самых запущенных случаев
И снова кошачий корм. На этот раз он оказался под воздействием влаги на протяжении пары недель
Предыстории нет, но выглядит пушисто
Пленка из всяких организмов на поверхности воды в кастрюле
Булочка, которая хочет стать красивой
Плесень на джеме приняла забавную форму. Мяу!
Обнаружено в холодильнике. Предположительно, это картофельное пюре
Консервированные персики
Автор фото поясняет, что неожиданно оказался с пневмонией в больнице, потому хозяйство на полторы недели осталось без присмотра. Кто завелся в кастрюле и можно ли его приручить, неизвестно
Мягкий сыр
Мимишная плесень. Ну и что теперь с ней делать?
Тут виден процесс заражения поверхности
Внутри банки арбузного сока плавают вовсе не пушистые кусочки арбуза
Красное вино. Было
Сахар, который пролежал в баночке 20 лет
Наш канал в Telegram. Присоединяйтесь!
Есть о чем рассказать? Пишите в наш телеграм-бот. Это анонимно и быстро